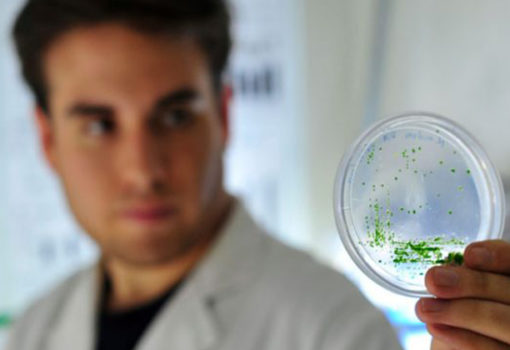
Innovación y vocación regional

CUP se reúne con la Red de Investigadores NEXOS Chile USA
El pasado 06 de junio, se realizó un encuentro entre los representantes de la Red de Investigadores Chilenos en EE.UU, Nexos Chile USA y la Corporación de Universidades Privadas – CUP. El objetivo de esta reunión fue debatir propuestas conjuntas para potenciar la investig...